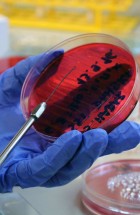
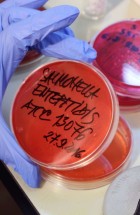
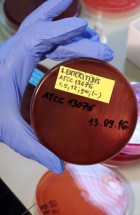
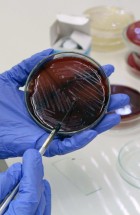
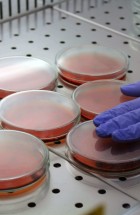
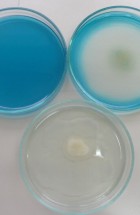
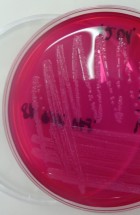
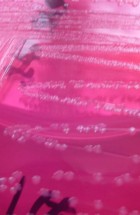
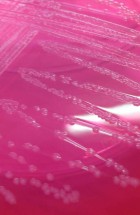
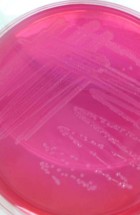

Šef Odeljenja
Dr vet. Oliver Radanović, vet spec.
Saradnici na odeljenju
Dr sci. vet. med. Nemanja Zdravković, viši naučni saradnik
Dr sci. vet. med. Ana Vasić, viši naučni saradnik
Tehnički saradnici na odeljenju
Slavica Savić, tehnički saradnik
Slađana Šaša, tehnički saradnik
Opis osnovnih aktivnosti na odeljenju
Odeljenje za bakteriologiju i parazitologiju vrši ispitivanja prisustva, izolacije, identifikacije i tipizacije patogenih bakterija, gljivica i parazita u materijalu poreklom od domaćih i divljih životinja, kao i u namirnicama životinjskog porekla i životnoj sredini. Na odeljenju se sprovode i ispitivanje antimikrobne osetljivosti na različite antimikrobne supstance i dezinfekciona sredstva. U svom radu Odeljenje za bakteriologiju i parazitologiju pored klasičnih mikrobioloških i parazitoloških metoda primenjuje i savremene molekularne metode. Za potrebe primarne poljoprivredne proizvodnje proizvodi biološke preparate namenjene za aktivnu imunizaciju životinja.
Aktivnosti na Odeljenju
- Izolacija i identifikacija mikroorganizama
- Ispitivanje antimikrobne osetljivosti mikroorganizama
- Molekularna dijagnostika bakterijskih, gljivičnih i parazitskih bolesti
- Tipizacija mikroorganizama
- Priprema inaktivnisanih bioloških preparata
- Dijagnostika bolesti pčela
- Ispitivanje prisustva i identifikacija parazita kod domaćih i divljih životinja, u uzorcima namirnica animalnog porekla, kao i iz životne sredine
- Determinacija vrsta artropodnih vektora
- Spisak metoda:
Odeljenje za bakteriologiju i parazitologiju sprovodi bakteriološka, mikološka i prazitološka ispitivanja uzoraka životinja (psi, mačke, konji, kunići, papagaji, svinje, goveda, ovce, koze, pernata živina, laboratorijske životinje i drugih vrsta).
| Redni broj | Naziv metode | Vrsta uzorka |
| 1. | Kompletno aerobno ispitivanje materijala uzoraka životinja (psi, mačke, konji, kunići, papagaji, svinje, goveda, ovce, koze, pernata živina i dr.) |
Biološki materijal poreklom od životinja: – organi – sekreti – ekskreti – tkiva – tkivne tečnosti – brisevi
|
| 2. | Kompletno anaerobno ispitivanje materijala | |
| 3. | Kompletno mikroaerofilno ispitivanje materijala | |
| 4. | Antibiogram – disk difuziona metoda | Bakterijski izolat |
| 5.
|
Antibiogram – mikrodiluciona metoda | |
| 6. | Identifikacija i tipizacija bakterija – klasična | |
| 7. | Identifikacija i tipizacija bakterija – aglutinacija | |
| 8. | Bakteriološki pregled mleka na mastitise (ZPV) | Mleko |
| 9. | Bakteriološki pregled – sperme – spermokultura – materična sluz | Sperma, materični bris |
| 10. | Bakteriološki pregled – urina – urinokultura | Urin |
| 11. | Bakteriološki pregled – feces | Feces |
| 12. | Hemokultura – aerobno | Puna krv |
| 13. | Hemokultura – anaerobno | Puna krv |
| 14. | Utvrđivanje prisustva genoma bakterija Leptospira sp. (real time PCR) | Biološki materijal poreklom od životinja:
– organi – sekreti – ekskreti – tkiva – tkivne tečnosti – brisevi
|
| 15. | Utvrđivanje prisustva genoma bakterija uzročnika bruceloze (real time PCR) | |
| 16. | Utvrđivanje prisustva genoma uzročnika Q groznice (real time PCR) | |
| 17. | Utvrđivanje prisustva genoma uzročnika hlamidioze (real time PCR) | |
| 18. | Utvrđivanje prisustva genoma uzročnika neosporoze (real time PCR) | |
| 19. | Utvrđivanje prisustva genoma Mycoplasma hyopneumoniae (real time PCR) | |
| 20. | Utvrđivanje prisustva genoma uzročnika toksoplazmoze (real time PCR) | |
| 21. | Izolacija bakterija uzročnika listerioze, identifikacija Listeria monocytogenes | |
| 22. | Izolacija bakterija uzročnika goveđe genitalne kampilobakterioze | |
| 23. | Izolacija i identifikacija Staphylococcus aureus | |
| 24. | Izolacija i identifikacija Streptococcus agalactiae | |
| 25. | Izolacija i identifikacija Salmonella | Biološki materijal poreklom od životinja
– feces, organi, sekret i ekskreti, tkiva, tkivne tečnosti, brisevi, embrionirana jaja, priplodna jaja, podloške iz transportnih kutija, prostirka |
| 26. | Utvrđivanje prisustva uzročnika varoze | Biološki materijal poreklom od životinja-pčela:
– Cela pčela – Pčelinje leglo – Debris |
| 27. | Utvrđivanje prisustva uzročnika etinoze | |
| 28. | Utvrđivanje prisustva uzročnika tropileloze | |
| 29. | Utvrđivanje prisustva uzročnika nozemoze | Biološki materijal poreklom od životinja-pčela:
– Cela pčela |
| 30. | Utvrđivanje prisustva spora uzročnika američke kuge pčelinjeg legla (mikroskopski pregled) | Biološki materijal poreklom od životinja-pčela:
– Pčelinje leglo |
| 31. | Determinacija vrsta artropodnih vektora | Biološki materijal- insekti, krpelji |